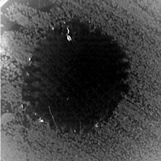

Kevlar®, Nomex®, and VAR Modification by Small Organic Molecules Anchoring: Transfusing Antibacterial Properties and Improving Water Repellency
Abstract
1. Introduction
2. Materials and Methods
2.1. Materials
2.2. Modification Methods

- Anchoring of ADMH onto Nomex® (NOM2)
- Chlorination procedure of NOM3
- Anchoring of APTAC onto KEVLAR® (KEV1, see Figure 2 below)

- Anchoring of APTAC onto Nomex®(NOM1)
- Anchoring of APTAC onto VAR (VAR1)
2.3. Characterization Methods of Modified Fabrics
- Wettability
- Antibacterial activity
3. Discussion
- Characterization and morphology of the Kevlar®, Nomex®, and VAR surfaces
- Scanning Electron Microscopy
- Wettability
- Antibacterial properties
4. Conclusions
Author Contributions
Funding
Institutional Review Board Statement
Informed Consent Statement
Data Availability Statement
Acknowledgments
Conflicts of Interest
Sample Availability
References
- Tomes, C.; Orr, R.M.; Pope, R. The impact of body armor on physical performance of law enforcement personnel: A systematic review. Ann. Occup. Environ. Med. 2017, 29, 14. [Google Scholar] [CrossRef] [PubMed]
- National Research Council. Testing of Body Armor Materials Phase III; The National Academies Press: Washington, DC, USA, 2012.
- Malbon, C.; Carr, D. Textiles for Military and Law Enforcement Personnel in High Performance Technical Textiles; Paul, R., Ed.; John Wiley & Sons Ltd.: Hoboken, NJ, USA, 2019. [Google Scholar]
- Schram, B.; Orr, R.; Pope, R.; Hinton, B.; Norris, G. Comparing the Effects of Different Body Armor Systems on the Occupational Performance of Police Officers. Int. J. Environ. Res. Public Health 2018, 15, 893. [Google Scholar] [CrossRef] [PubMed]
- Hillermeier, K. Prospects of Aramid as a Substitute for Asbestos. Text. Res. J. 1984, 54, 575–580. [Google Scholar] [CrossRef]
- Yang, H.M. Aramid Fibers. In Comprehensive Composite Materials; Kelly, A., Zweben, C., Eds.; Pergamon Press: Pergamon, Turkey, 2000; pp. 199–229. [Google Scholar]
- Sun, Y.; Sun, G. Novel refreshable N-halamine polymeric biocides: Grafting hydantoin-containing monomers onto high performance fibers by a continuous process. J. Appl. Polym. Sci. 2003, 88, 1032–1039. [Google Scholar] [CrossRef]
- Sun, Y.; Sun, G. Durable and Regenerable Antimicrobial Textile Materials Prepared by a Continuous Grafting Process. J. Appl. Polym. Sci. 2002, 84, 1592–1599. [Google Scholar] [CrossRef]
- Mosaad, R.M.; Alhalafi, M.H.; Emam, E.-A.M.; Ibrahim, M.A.; Ibrahim, H. Enhancement of Antimicrobial and Dyeing Properties of Cellulosic Fabrics via Chitosan Nanoparticles. Polymers 2022, 14, 4211, An alternative method for the anchoring of ADMH onto Kevlar was published here. [Google Scholar] [CrossRef]
- Fink, J.K. Aramids. In High Performance Polymers, 2nd ed.; Fink, J.K., Ed.; William Andrew Publishing: Norwich, NY, USA, 2014; pp. 301–320. [Google Scholar]
- Ahmad, S.; Ullah, T.; Ziauddin. Fibers for Technical Textiles; Ahmad, S., Rasheed, A., Nawab, Y., Eds.; Springer: Cham, Switzerland, 2020; pp. 21–48. [Google Scholar]
- Simon, M.; Fulchiron, R.; Gouanvé, F. Water Sorption and Mechanical Properties of Cellulosic Derivative Fibers. Polymers 2022, 14, 2836. [Google Scholar] [CrossRef]
- Yudaev, P.A.; Tamboura, B.; Chistyakov, E.M. Antistatic polymeric materials. Nanotechnologies Constr. 2023, 15, 139–151. [Google Scholar] [CrossRef]
- Liu, S.; Sun, G. Radical graft functional modification of cellulose with allyl monomers: Chemistry and structure characterization. Carbohydr. Polym. 2008, 71, 614–625. [Google Scholar] [CrossRef]
- Han, X.; Wang, Y.; Wang, Z.; Li, X.; Liu, Y.; Wang, C.; Yan, F.; Wang, J. Interfacial polymerization plus: A new strategy for membrane selective layer construction. J. Membr. Sci. 2022, 642, 119973. [Google Scholar] [CrossRef]
- Worley, S.; Williams, D.; Crawford, R.A. Halamine water disinfectants. Crit. Rev. Environ. Sci. Technol. 1988, 18, 133–175. [Google Scholar] [CrossRef]
- Zhu, C.; Chang, D.; Wang, X.; Chai, D.; Chen, L.; Dong, A.; Gao, G. Novel Antibacterial Fibers of Amphiphilic N-Halamine Polymer Prepared by Electrospinning. Polym. Adv. Technol. 2019, 30, 1386–1393. [Google Scholar] [CrossRef]
- Liu, Y.; Ren, X.; Huang, T.S. Antimicrobial Cotton Containing N-Halamine and Quaternary Ammonium Groups by Grafting Copolymerization. Appl. Surf. Sci. 2014, 296, 231–236. [Google Scholar] [CrossRef]
- Bhuyan, M.M.; Okabe, H.; Hidaka, Y.; Hara, K. Pectin-[(3-acrylamidopropyl) trimethylammonium chloride-co -acrylic acid] hydrogel prepared by gamma radiation and selectively silver (Ag) metal adsorption. J. Appl. Polym. Sci. 2017, 135, 45906. [Google Scholar] [CrossRef]
- Zhou, P.; Li, X.; Yuan, H.; Zhou, J.; Qu, L.; Yang, Y.; He, G.; Luo, C. A Long-Acting Hygroscopic and Antibacterial Composite Filler: A New Approach to Phytoextraction Solid Residues from Citrus aurantium L. Ind. Crops Prod. 2022, 187 Pt B, 115505. [Google Scholar] [CrossRef]
- Matsumura, S.; Hlil, A.R.; Lepiller, C.; Gaudet, J.; Guay, D.; Shi, Z.; Holdcroft, S.; Hay, A.S. Stability and Utility of Pyridyl Disulfide Functionality in RAFT and Conventional Radical Polymerizations. J. Polym. Sci. Part A Polym. Chem. 2008, 46, 7207–7224. [Google Scholar] [CrossRef]
- Bhuyan, M.M.; Jeong, J.H. Synthesis and Characterization of Gamma Radiation Induced Diallyldimethylammonium Chloride-Acrylic Acid-(3-Acrylamidopropyl) Trimethylammonium Chloride Superabsorbent Hydrogel. Gels 2023, 9, 159. [Google Scholar] [CrossRef]
- Amiri, S. Synthesis and characterization of acrylamide/(3-acrylamidopropyl) trimethyl ammonium chloride solution and acrylamide/Na-montmorillonite hydrogels via controlled radical polymerization for use as high-temperature and high-salinity oil reservoirs. Polym. Bull. 2019, 76, 683–699. [Google Scholar] [CrossRef]
- Constantin, M.; Mihalcea, I.; Oanea, I.; Harabagiu, V.; Fundueanu, G. Studies on Graft Copolymerization of 3-Acrylamidopropyl Trimethylammonium Chloride on Pullulan. Carbohydr. Polym. 2011, 84, 926–932. [Google Scholar] [CrossRef]
- Sun, Y.; Sun, G. Durable and refreshable polymeric N-halamine biocides containing 3-(4′-vinylbenzyl)-5,5-dimethylhydantoin. J. Polym. Sci. A Polym. Chem. 2001, 39, 3348–3355. [Google Scholar] [CrossRef]
- Lachowicz, D.; Mielczarek, P.; Wirecka, R.; Berent, K.; Karewicz, A.; Szuwarzyński, M.; Zapotoczny, S. Nanohydrogels Based on Self-Assembly of Cationic Pullulan and Anionic Dextran Derivatives for Efficient Delivery of Piroxicam. Pharmaceutics 2019, 11, 622. [Google Scholar] [CrossRef] [PubMed]
- Nemani, S.K.; Annavarapu, R.K.; Mohammadian, B.; Raiyan, A.; Heil, J.; Haque, M.A.; Abdelaal, A.; Sojoudi, H. Surface Modification: Surface Modification of Polymers: Methods and Applications. Adv. Mater. Interfaces 2018, 5, 1801247. [Google Scholar] [CrossRef]
- Niu, T.; Wang, X.; Wu, C.; Sun, D.; Zhang, X.; Chen, Z.; Fang, L. Chemical Modification of Cotton Fabrics by a Bifunctional Cationic Polymer for Salt-Free Reactive Dyeing. ACS Omega 2020, 5, 15409–15416. [Google Scholar] [CrossRef] [PubMed]
- Yudaev, P.; Chuev, V.; Klyukin, B.; Kuskov, A.; Mezhuev, Y.; Chistyakov, E. Polymeric Dental Nanomaterials: Antimicrobial Action. Polymers 2022, 14, 864. [Google Scholar] [CrossRef]
- Yudaev, P.; Mezhuev, Y.; Chistyakov, E. Nanoparticle-Containing Wound Dressing: Antimicrobial and Healing Effects. Gels 2022, 8, 329. [Google Scholar] [CrossRef]
- Cai, R.; Glinel, K.; De Smet, D.; Vanneste, M.; Mannu, N.; Kartheuser, B.; Nysten, B.; Jonas, A.M. Environmentally Friendly Super-Water-Repellent Fabrics Prepared from Water-Based Suspensions. ACS Appl. Mater. Interfaces 2018, 10, 15346–15351. [Google Scholar] [CrossRef]
- Zhang, Z.; Wang, Z.; Wang, J.; Wang, S. Enhancing chlorine resistances and anti-biofouling properties of commercial aromatic polyamide reverse osmosis membranes by grafting 3-allyl-5,5-dimethylhydantoin and N,N′-Methylenebis(acrylamide). Desalination 2013, 309, 187–196. [Google Scholar] [CrossRef]
- Wei, X.; Wang, Z.; Zhang, Z.; Wang, J.; Wang, S. Surface modification of commercial aromatic polyamide reverse osmosis membranes by graft polymerization of 3-allyl-5,5-dimethylhydantoin. J. Membr. Sci. 2010, 351, 222–233. [Google Scholar] [CrossRef]
- Li, L.; Zhao, N.; Liu, S. Versatile Surface Biofunctionalization of Poly(Ethylene Terephthalate) by Interpenetrating Polymerization of a Butynyl Monomer Followed by “Click Chemistry”. Polymer 2012, 53, 67–78. [Google Scholar] [CrossRef]
- Heliopoulos, N.S.; Galeou, A.; Papageorgiou, S.K.; Favvas, E.P.; Katsaros, F.K.; Stamatakis, K. An in situ antimicrobial susceptibility testing method based on in vivo measurements of chlorophyll α fluorescence. J. Microbiol. Meth. 2015, 112, 49–54. [Google Scholar] [CrossRef]
- Heliopoulos, N.S.; Galeou, A.; Papageorgiou, S.K.; Favvas, E.P.; Katsaros, F.K.; Stamatakis, K. Modified in situ antimicrobial susceptibility testing method based on cyanobacteria chlorophyll a fluorescence. J. Microbiol. Meth. 2016, 121, 1–4. [Google Scholar] [CrossRef] [PubMed]
- Rippka, R.; Deruelles, J.; Waterbury, J.B.; Herdman, M.; Stanier, R.Y. Generic Assignments, Strain Histories and Properties of Pure Cultures of Cyanobacteria. Microbiology 1979, 111, 1–61. [Google Scholar] [CrossRef]
- Stamatakis, K.; Papageorgiou, G.C. The osmolality of the cell suspension regulates phycobilisome-to-photosystem I excitation transfers in cyanobacteria. Biochim. Biophys. Acta Bioenerg. 2001, 1506, 172–181. [Google Scholar] [CrossRef]
- Moran, P. Formulae for Determination of Chlorophyllous Pigments Extracted with N,N-Dimethylformamide. Plant Physiol. 1982, 69, 1376–1381. [Google Scholar] [CrossRef]
- Ellinas, K.; Kefallinou, D.; Stamatakis, K.; Gogolides, E.; Tserepi, A. Is There a Threshold in the Antibacterial Action of Superhydrophobic Surfaces? ACS Appl. Mater. Interfaces 2017, 9, 39781–39789. [Google Scholar] [CrossRef] [PubMed]
- Kefallinou, D.; Ellinas, K.; Speliotis, T.; Stamatakis, K.; Gogolides, E.; Tserepi, A. Optimization of Antibacterial Properties of “Hybrid” Metal-Sputtered Superhydrophobic Surfaces. Coatings 2020, 10, 25. [Google Scholar] [CrossRef]
- Heliopoulos, N.S.; Kouzilos, G.N.; Giarmenitis, A.I.; Papageorgiou, S.K.; Stamatakis, K.; Katsaros, F.Κ. Viscose Fabric Functionalized with Copper and Copper Alginate Treatment Toward Antibacterial and UV Blocking Properties. Fibers Polym. 2020, 21, 1238–1250. [Google Scholar] [CrossRef]
- Islam, S.; Hasan, M.; Ahmad, M.B. Chemical Modification and Properties of Cellulose-Based Polymer Composites. In Lignocellulosic Polymer Composites; Thakur, V.K., Ed.; John Wiley & Sons, Inc.: Hoboken, NJ, USA, 2015. [Google Scholar] [CrossRef]
- Mahdavi, H.; Amirsadeghi, M. Synthesis and Applications of Quaternized Highly Branched Polyacrylamide as a Novel Multi-Site Polymeric Phase Transfer Catalyst. J. Iran. Chem. Soc. 2013, 10, 791–797. [Google Scholar] [CrossRef]
- Ou, R.; Zhao, H.; Sui, S.; Song, Y.; Wang, Q. Reinforcing effects of Kevlar fiber on the mechanical properties of wood-flour/high-density-polyethylene composites. Compos. Part A Appl. Sci. 2010, 41, 1272–1278. [Google Scholar] [CrossRef]
- Yuan, J.; Zhang, Z.; Yang, M.; Li, P.; Men, X.; Liu, W. Graphene Oxide-Grafted Hybrid-Fabric Composites with Simultaneously Improved Mechanical and Tribological Properties. Tribol. Lett. 2018, 66, 28. [Google Scholar] [CrossRef]
- Satha, H.; Kouadri, I.; Benachour, D. Thermal, Structural and Morphological Studies of Cellulose and Cellulose Nanofibers Extracted from Bitter Watermelon of the Cucurbitaceae Family. J. Polym. Environ. 2020, 28, 1914–1920. [Google Scholar] [CrossRef]
- Abderrahim, B.; Abderrahman, E.; Mohamed, A.; Fatima, T.; Abdesselam, T.; Krim, O. Kinetic Thermal Degradation of Cellulose, Polybutylene Succinate and a Green Composite: Comparative Study. J. Environ. Eng. 2015, 3, 95–110. [Google Scholar] [CrossRef]
- Washer, G.; Brooks, T.; Saulsberry, R. Characterization of Kevlar Using Raman Spectroscopy. J. Mater. Civ. Eng. 2009, 21, 226–234. [Google Scholar] [CrossRef]
- Sun, Y.; Chen, W.; Zhou, X. Thermal insulation fibers with a Kevlar aerogel core and a porous Nomex shell. RSC Adv. 2021, 11, 34828–34835. [Google Scholar] [CrossRef] [PubMed]
- Zahid, M.; Mazzon, G.; Athanassiou, A.; Bayer, I.S. Environmentally benign non wettable textile treatments: A review of recent state-of-the-art. Adv. Colloid Interface Sci. 2019, 270, 216–250. [Google Scholar] [CrossRef] [PubMed]
- Su, M.; Xia, D.; Teng, P.; Nimmagadda, A.; Zhang, C.; Odom, T.; Cao, A.; Hu, Y.; Cai, J. Membrane-Active Hydantoin Derivatives as Antibiotic Agents. J. Med. Chem. 2017, 60, 8456–8465. [Google Scholar] [CrossRef]
- Demir, B.; Broughton, R.M.; Qiao, M.; Huang, T.-S.; Worley, S.D. N-Halamine Biocidal Materials with Superior Antimicrobial Efficacies for Wound Dressings. Molecules 2017, 22, 1582. [Google Scholar] [CrossRef]
- Chen, Z.; Sun, Y. N-Halamine-Based Antimicrobial Additives for Polymers: Preparation, Characterization, and Antimicrobial Activity. Ind. Eng. Chem. Res. 2006, 45, 2634–2640. [Google Scholar] [CrossRef]
- Wang, Y.; Yin, M.; Lin, X.; Li, L.; Li, Z.; Ren, X.; Sun, Y. Tailored synthesis of polymer-brush-grafted mesoporous silicas with N-halamine and quaternary ammonium groups for antimicrobial applications. J. Colloid Interface Sci. 2019, 533, 604–611. [Google Scholar] [CrossRef]












![]() | ![]() | ![]() | ![]() | |
![]() | ![]() | ![]() | ![]() | |
| Growth | heavy | none/slight | none | none |
| Assessment | - | good effect/ limit of efficacy | good effect | good effect |
| (a) Untreated Kevlar® | (b) KEV1 | (c) KEV2 | (d) KEV3 |
![]() | ![]() | ![]() | ![]() | |
![]() | ![]() | ![]() | ![]() | |
| Growth | heavy | slight | none | none |
| Assessment | - | limit of efficacy | good effect | good effect |
| (a) Untreated Nomex® | (b) NOM1 | (c) NOM2 | (d) NOM3 |
![]() | ![]() | |
![]() | ![]() | |
| Growth | heavy | none/slight |
| Assessment | - | good effect/ limit of efficacy |
| (a) Untreated VAR | (b) VAR1 |
| untreated Kevlar® | KEV1 | KEV2 | KEV3 | |
| Π7 | 0.0 | 97.3 | 113.6 | 120.5 |
| untreated Nomex® | NOM1 | NOM2 | NOM3 | |
| Π10 | 0.0 | 86.3 | 115.1 | 118.1 |
| untreated VAR | VAR1 | |||
| Π10 | 0.0 | 98.3 |
Disclaimer/Publisher’s Note: The statements, opinions and data contained in all publications are solely those of the individual author(s) and contributor(s) and not of MDPI and/or the editor(s). MDPI and/or the editor(s) disclaim responsibility for any injury to people or property resulting from any ideas, methods, instructions or products referred to in the content. |
© 2023 by the authors. Licensee MDPI, Basel, Switzerland. This article is an open access article distributed under the terms and conditions of the Creative Commons Attribution (CC BY) license (https://creativecommons.org/licenses/by/4.0/).
Share and Cite
Frousiou, E.; Tonis, E.; Rotas, G.; Pantelia, A.; Chalkidis, S.G.; Heliopoulos, N.S.; Kagkoura, A.; Siamidis, D.; Galeou, A.; Prombona, A.; et al. Kevlar®, Nomex®, and VAR Modification by Small Organic Molecules Anchoring: Transfusing Antibacterial Properties and Improving Water Repellency. Molecules 2023, 28, 5465. https://doi.org/10.3390/molecules28145465
Frousiou E, Tonis E, Rotas G, Pantelia A, Chalkidis SG, Heliopoulos NS, Kagkoura A, Siamidis D, Galeou A, Prombona A, et al. Kevlar®, Nomex®, and VAR Modification by Small Organic Molecules Anchoring: Transfusing Antibacterial Properties and Improving Water Repellency. Molecules. 2023; 28(14):5465. https://doi.org/10.3390/molecules28145465
Chicago/Turabian StyleFrousiou, Efrosyni, Efstathios Tonis, Georgios Rotas, Anna Pantelia, Savvas G. Chalkidis, Nikolaos S. Heliopoulos, Antonia Kagkoura, Dionysios Siamidis, Angeliki Galeou, Anastasia Prombona, and et al. 2023. "Kevlar®, Nomex®, and VAR Modification by Small Organic Molecules Anchoring: Transfusing Antibacterial Properties and Improving Water Repellency" Molecules 28, no. 14: 5465. https://doi.org/10.3390/molecules28145465
APA StyleFrousiou, E., Tonis, E., Rotas, G., Pantelia, A., Chalkidis, S. G., Heliopoulos, N. S., Kagkoura, A., Siamidis, D., Galeou, A., Prombona, A., Stamatakis, K., Boukos, N., & Vougioukalakis, G. C. (2023). Kevlar®, Nomex®, and VAR Modification by Small Organic Molecules Anchoring: Transfusing Antibacterial Properties and Improving Water Repellency. Molecules, 28(14), 5465. https://doi.org/10.3390/molecules28145465